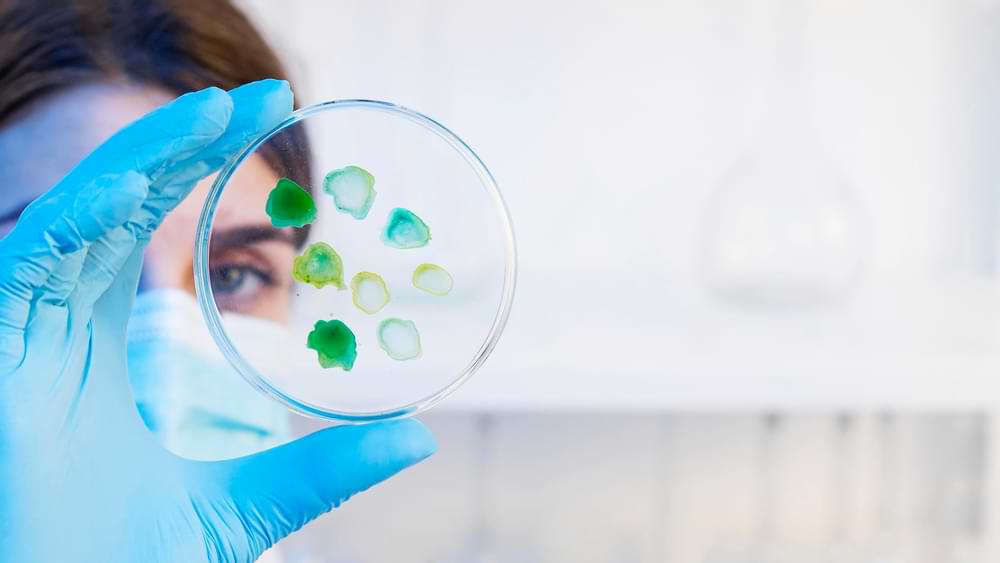

Celulele stem sunt utilizate în oncologie prin transplantul de măduvă osoasă, o procedură care a revoluționat tratamentul multor cancere hematologice.
Ce sunt celulele stem?
Aceste celule nediferențiate pot evolua în celule specializate – din sânge, piele, oase sau alte organe – datorită capacității lor de adaptare și dezvoltare.
Clasificarea celulelor stem
- Celule stem embrionare – provin din embrioni și pot deveni orice tip de celulă.
- Celule stem adulte – se găsesc în diverse țesuturi ale corpului, având un potențial de diferențiere mai limitat, dar esențiale pentru regenerarea naturală.
Terapia cu celule stem în tratamentul cancerului
Terapia cu celule stem presupune utilizarea acestor celule pentru a înlocui sau repara celule bolnave sau deteriorate. În context oncologic, scopurile principale sunt:
- Restabilirea producției normale de celule sanguine după chimioterapie sau radioterapie agresivă.
- Refacerea sistemului imunitar al pacientului pentru a combate mai eficient cancerul și eventualele infecții.
Sursă de celule stem utilizate în tratament
- Autologe – celulele stem ale pacientului.
- Alogenice – celule stem de la un donator compatibil.
- Sângele din cordonul ombilical – o sursă bogată, frecvent folosită în pediatrie.
Transplantul de măduvă osoasă
Este cea mai răspândită formă de terapie cu celule stem în oncologie și este esențial pentru cancerele hematologice, cum ar fi:
- Leucemia (acută sau cronică).
- Limfomul Hodgkin și non‑Hodgkin.
- Mielomul multiplu.
Procedura înlocuiește măduva osoasă bolnavă cu celule stem sănătoase, care regenera globulele albe, roșii și trombocitele.
Refacerea sistemului imunitar
După chimioterapie și radioterapie, sistemul imunitar este grav afectat. Celulele stem accelerează refacerea acestuia, permițând corpului să lupte mai bine împotriva infecțiilor și să gestioneze efectele secundare ale tratamentelor oncologice.
Integrarea în imunoterapie
Celulele stem sunt folosite în terapii avansate precum CAR‑T (Chimeric Antigen Receptor T‑Cell), unde celulele imune ale pacientului sunt reprogramate genetic pentru a recunoaște și distruge celulele canceroase.
Terapia personalizată
Prin utilizarea celulelor stem, se pot dezvolta tratamente adaptate profilului genetic și nevoilor individuale ale fiecărui pacient, sporind eficacitatea și reducând riscul de efecte adverse.
Tipuri de transplanturi de celule stem
Transplant autolog
Celulele stem sunt recoltate din corpul pacientului înainte de tratamentul agresiv (de exemplu, chimioterapie sau radioterapie) și reinfuzate ulterior pentru a susține regenerarea țesuturilor.
- Avantaje:
- Risc scăzut de respingere.
- Compatibilitate perfectă.
- Dezavantaje:
- Posibilitatea reintroducerii celulelor canceroase, dacă acestea nu sunt complet eliminate înainte de reinfuzare.
Transplant alogen
Folosește celule stem de la un donator compatibil, fie un membru al familiei, fie un voluntar.
- Avantaje:
- Efectul „grefă contra tumorii”, în care celulele transplantate contribuie la eliminarea celulelor canceroase rămase.
- Dezavantaje:
- Risc de boala grefă contra gazdei (GVHD).
- Necesitatea găsirii unui donator compatibil.
Transplant din sângele din cordonul ombilical
Celulele stem din cordonul ombilical sunt o sursă valoroasă, în special pentru copii. Aceste celule prezintă un risc redus de respingere și nu necesită o compatibilitate perfectă.
Riscuri și limitări ale terapiei cu celule stem
Deși reprezintă o inovație majoră, terapia cu celule stem implică anumite complicații:
- Boala grefă contra gazdei (GVHD) – celulele transplantate atacă țesuturile gazdei.
- Infecții – datorate unui sistem imunitar slăbit.
- Rejetul transplantului – respingerea celulelor stem de către organism.
- Toxicitatea tratamentului pre‑transplant – efecte secundare severe ale chimioterapiei și radioterapiei utilizate pentru pregătirea corpului.
Nu toate tipurile de cancer pot beneficia de această terapie; succesul depinde de stadiul bolii, vârsta și starea generală de sănătate a pacientului.
Viitorul terapiei cu celule stem în oncologie
Cercetările avansează rapid, deschizând noi perspective în lupta împotriva cancerului:
- Terapia genetică avansată – utilizarea celulelor stem modificate genetic pentru a viza mai eficient tumorile.
- Medicina regenerativă – repararea țesuturilor deteriorate de cancer sau de tratamentele oncologice.
- Imunoterapia combinată – integrarea celulelor stem în protocoale care stimulează răspunsul imunitar anti‑cancer.
Terapia cu celule stem rămâne una dintre cele mai promițătoare abordări în tratamentul cancerului, oferind șanse reale de recuperare și îmbunătățirea calității vieții pacienților.